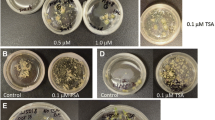

Abstract
Genotype-limited plant regeneration is one of the main obstacles to the broader use of genetic transformation in barley breeding. Thus, developing new approaches that might improve responses of in vitro recalcitrant genotypes remains at the center of barley biotechnology. Here, we analyzed different barley genotypes, including “Golden Promise,” a genotype commonly used in the genetic transformation, and four malting barley cultivars of poor regenerative potential. The expression of hormone-related transcription factor (TF) genes with documented roles in plant regeneration was analyzed in genotypes with various plant-regenerating capacities. The results indicated differential expression of auxin-related TF genes between the barley genotypes in both the explants and the derived cultures. In support of the role of auxin in barley regeneration, distinct differences in the accumulation of free and oxidized auxin were observed in explants and explant-derived callus cultures of barley genotypes. Following the assumption that modifying gene expression might improve plant regeneration in barley, we treated the barley explants with trichostatin A (TSA), which affects histone acetylation. The effects of TSA were genotype-dependent as TSA treatment improved plant regeneration in two barley cultivars. TSA-induced changes in plant regeneration were associated with the increased expression of auxin biosynthesis-involved TFs. The study demonstrated that explant treatment with chromatin modifiers such as TSA might provide a new and effective epigenetic approach to improving plant regeneration in recalcitrant barley genotypes.
Similar content being viewed by others
Introduction
Barley (Hordeum vulgare L.) is the fourth most important cereal in the world after corn (Zea mays), rice (Oryza sativa), and wheat (Triticum aestivum). In 2021, barley world production reached 145 million tons, with a global area of spring barley cultivation of almost 50 million hectares (FAO, https://www.fao.org/faostat/en/#home). The high starch and protein content in barley grains predisposes this cereal to be used in different industries, including brewing and food production for animals and humans (Baik and Ullrich 2008) and recombinant protein production (Yemets et al. 2011).
A long history of cultivation and adaptation to a wide range of agro-climatic conditions resulted in a huge genetic diversity of barley that was estimated by SNPs for 60–90% based on analysis of 96 spring barley cultivars and 260 Ethiopian barley accessions (Bykova et al. 2017; Teklemariam et al. 2022). Barley cultivars and breeding lines show great plant and grain morphology diversity and tolerance to environmental stresses, including resistance to temperature and drought (Dawson et al. 2015; Jabbari et al. 2018). In addition to a high position in plant breeding, and due to a diploid chromosome number, self-pollination, and public access to the genome sequence, barley has also been recommended as a model plant for research on the Triticeae tribe, such as polyploid wheat or rye (Secale cereale) (Saisho and Takeda 2011).
In recent years, genetic transformation has become a central tool in the research and breeding of crops, including cereals (Anjanappa and Gruissem 2021). A prerequisite for implementing genetic transformation protocol is the efficient regeneration of plants from transgenic tissues. The strong genotypic effect on in vitro plant regeneration substantially limits the routine use of modern biotechnology tools in some crops, including cereals and among them barley (Lü et al. 2015; Hayta et al. 2019; Debernardi et al. 2020).
In barley, the routine production of transgenic lines in the culture of somatic tissue is limited to a few genotypes, and “Golden Promise” (GP) is the most commonly used in agrotransformation (Matres et al. 2021). However, inferior agronomic characteristics compared to modern elite barley cultivars, including a low yield and sensitivity to diseases, particularly powdery mildew, substantially limit use of GP in breeding programs (Douchkov et al. 2014). Genetic transformation for a few other genotypes, including “Scarlett”, was also reported but with limited success (Nadolska-Orczyk et al. 2000; Zalewski et al. 2012). Unfortunately, most barley cultivars remain recalcitrant to genetic transformation due to the low plant regeneration capacity (Harwood 2012; Orman-Ligeza et al. 2020).
Besides genotype, the effectiveness of plant regeneration in vitro is affected by various exo- and endogenous factors (Bidabadi and Mohan Jain 2020). In barley, the optimization of in vitro culture protocols involved chemical and physical culture conditions, in particular, the composition of media, including the macro- and micronutrients, the plant-growth regulators (PGRs), and the explant type (Dahleen and Bregitzer 2002; Chauhan and Kothari 2004; Ganeshan et al. 2006). In barley protocols, the callus induced from the explants on CIM (callus induction medium) is transferred onto PRM (plant regeneration medium) to regenerate plants. The CIM and PRM media substantially differ in PGR composition, and depending on the protocol, various PGRs have been recommended, including Dicamba, 6-benzylaminopurine (BAP), or 2,4-dichlorophenoxyacetic acid, to regenerate barley plants efficiently (Chang et al. 2003; Serhantova et al. 2004; Hensel et al. 2009). In line with media optimization, different explants have been evaluated, mature and immature zygotic embryos (IZEs) at different developmental stages and embryo fragments have been recommended for effective plant regeneration (Chang et al. 2003; Senarath 2007; Hensel et al. 2009).
Plant regeneration from the explant cells is a multi-staged developmental process controlled by a complex network of genetic and epigenetic factors (Bidabadi and Mohan Jain 2020). Studies on a model plant of Arabidopsis and other species revealed transcription factors (TFs), miRNAs, DNA methylation, and histone modifications to play a central role in plant regeneration in vitro (Shin et al. 2020; Wójcikowska et al. 2020; Salaün et al. 2021). In particular, TFs of regulatory functions in gene expression have been widely documented to control in vitro responses of plants (Salaün et al. 2021). Although hundreds of TFs of differential expression in plant regeneration were reported (Gliwicka et al. 2013; Wickramasuriya and Dunwell 2015; Lardon et al. 2020; Suo et al. 2021; Xu et al. 2022), only a few were functionally analyzed in terms of their role in the plant regeneration mechanism. The studies on Arabidopsis revealed the functions of several TFs, including BABY BOOM-BBM (Boutilier et al. 2002), LEAFY COTYLEDON1 and 2-LEC1 and LEC2 (Lotan et al. 1998; Gaj et al. 2005), WUSCHEL-WUS (Zuo et al. 2002), AGAMOUS-LIKE15-AGL15 (Harding et al. 2003), MYB118 (Wang et al. 2009), and EMBRYOMAKER-EMK (Tsuwamoto et al. 2010), in developmental cell reprogramming. Some of these TFs were also reported to be involved in the plant regeneration of other species, including barley (Heidmann et al. 2011; Belide et al. 2013; Guo et al. 2013; Brand et al. 2019; Suo et al. 2021). However, further analysis is necessary to identify the main regulators of plant regeneration in cereals including barley.
The advances in deciphering genetic networks controlling plant regeneration in vitro resulted in the development of a new “genetic strategy” to overcome limitations in plant regeneration of recalcitrant species (Lee and Wang 2023). Following this approach, transgenic lines that overexpressed TF genes, including BBM, LEC2, and efficiently regenerated plants, have been produced in Populus tomentosa, Capsicum annuum, and Brassica napus (Deng et al. 2009; Heidmann et al. 2011; Belide et al. 2013).
Here, we propose an “epigenetic approach” for improving plant regeneration in recalcitrant barley genotypes. We aimed to modify the epigenome of barley explant cells by treatment with an antifungal antibiotic, trichostatin A (TSA), of inhibitory effect on histone deacetylases (HDACs) (Tsuji et al. 1976; Furumai et al. 2001). Since HDAC enzymes remove the acetyl group from the ε-amino group of the lysine side chains (Seto and Yoshida 2014), TSA promotes the hyperacetylation of histones that might result in an open chromatin state and the transcription of genes, including those controlling plant regeneration (Görisch et al. 2005). In line with this assumption, TSA promotes the development of embryogenic tissue in seedlings (Tanaka et al. 2008), and in vitro cultured explants of Arabidopsis (Wójcikowska et al. 2018) and conifers (Picea abies and Pinus sylvestris) (Uddenberg et al. 2011; Abrahamsson et al. 2017). In addition to the vegetative explants, the beneficial effects of TSA on the microspore cultures of T. aestivum (Jiang et al. 2017) and B. napus (Li et al. 2014) have been documented. Interestingly, TSA treatment might recompense the need for auxin treatment, and TSA-treated Arabidopsis explants (IZEs) regenerated plants via somatic embryogenesis (SE) on a medium free of auxin, a key inducer of embryogenic transition (Wójcikowska et al. 2018). Thus, here we investigated the effect of TSA on plant regeneration of barley cultivars recalcitrant for the in vitro culture.
Materials and methods
Plant material
Five spring barley cultivars with divergent pedigrees were used: GP (UK) and four malting cultivars: “Morex” (USA), “Scarlett” (Germany), “Krona” (Germany), and “Dema” (Poland), except for the six-row cv. “Morex”, the rest of the cultivars are two-row. The barley cultivars have diverse genetic backgrounds. The malting cultivars resulted from the following crosses: “Dema”–“Aramir” × “Georgia”; “Krona”–(“Nebi” × “Trumpf”) × (“Union” × “Gimpel”); “Morex”–“Cree” × “Bonanza”; “Scarlett” × (“Amazone” × “Breun St. 2730”) × “Kym.” (Russell et al. 1997; https://grinczech.vurv.cz/gringlobal/search.aspx; https://beerandbrewing.com/dictionary/HzSYZgMg59/). The GP was a gamma-ray-induced mutant of “Maythorpe” (Russell et al. 1997).
Plant growth and in vitro culture conditions
The donor plants for the in vitro culture were grown at 18/16 °C for 3 weeks in a growth room at a 200 μM s−1 m−2 light intensity. Then the plants were transferred to a growth chamber with 17/14 °C day/night temperature conditions, 480–500 μM s−1 m−2 photon flux density of illumination, and 16/8 h photoperiod. The plant materials grown in sterile in vitro conditions were kept at 24 °C under a 16/8 h photoperiod of 40 μM m−2 s−1 white, fluorescent light.
Explants for in vitro culture
Seeds with IZEs of approximately 1.5–2 mm diameter were collected from the pot-growing plants, washed with 70% ethanol for 3 min with shaking, and then rinsed once with sterile distilled water. Then seeds were surface-sterilized in a solution of sodium hypochlorite (2.4%) containing a few drops of Tween20 for 15 min with shaking. Afterward, seeds were rinsed five times (1 min) in sterile, distilled water. The IZEs were isolated from the seeds, and the embryo axes were removed to isolate scutella, as described by Marthe et al. (2015). The scutella were used as explants for TSA treatment and in vitro culture.
Callus induction and regeneration
Ten isolated scutella were cultured in a Petri dish with an agar CIM supplemented with 2.5 mg/L Dicamba (Sigma-Aldrich, St. Louis, MO, USA) (Supplementary Table 1) in dark conditions. After 2 weeks, scutella-derived calli were transferred to a fresh CIM medium for the next 2 weeks. Then, the explants were transferred to plant regeneration (K4NB) medium-PRM with a 0.225 mg/L BAP (Sigma-Aldrich, St. Louis, MO, USA) (Supplementary Table 1) and cultured in the light (growth conditions described in a section on “Plant growth and in vitro culture conditions”). The medium was refreshed every 2 weeks, and after 4 weeks on the PRM medium, the explant capacity for plant regeneration was analyzed.
Explants treatment with TSA
To analyze the effect of TSA, an inhibitor of HDACs, on the plant regeneration capacity of explants, the CIM medium was supplemented with trichostatin TSA (Sigma Aldrich; St. Louis, MO, USA #T1952) at concentrations of 1.0, 2.5, 5.0, and 7.5 μM. The explants were cultured on the TSA-supplemented CIM medium for 1, 2, and 4 weeks.
Evaluation of regeneration capacity
The capacity for plant regeneration of 8-week-old cultures was evaluated. Plant regeneration efficiency (the percentage of explants that formed shoots) and plant regeneration productivity (the average number of shoots produced per regenerating explant) were scored. Each culture combination was evaluated in at least three replicates, and 30 explants (ten explants/Petri dish) were analyzed per one replicate.
Histological examination
The explants of “Golden Promise” cultured on PRM medium (35 and 42 days) were subjected to histological examination. The plant tissue was fixed in a mixture of 3% (w/v) paraformaldehyde (Sigma-Aldrich, St. Louis, MO, USA) and 1.25% (v/v) glutaraldehyde (Sigma-Aldrich, St. Louis, MO, USA) in PBS (phosphate-buffered saline, pH 7.2). Samples were de-aerated in fixative for 2 h, and incubated in fixative overnight at 4 °C. After rinsing with PBS (3 × 20 min), the plant material was dehydrated in an ethanol series (10, 30, 50, 70, 90, and 100%) and embedded in Steedman’s wax. The blocks with plant tissue were cut (for 8 μm thick) using a Zeiss HYRAX M40 rotary microtome (Jena, Germany) and collected on microscopic slides covered with poly-L-lysine (Menzel Gläser, Germany). The sections were dewaxed, rehydrated in a series of ethanol solutions (3 × 100%, 1 × 90%, 1 × 50% (v/v) solution, 1× distilled water; each wash for 10 min), and prepared for the histochemical analysis. We used two different staining methods, PAS (periodic-acid-Schiff) reaction and sequenced standing with methyl and toluidine blue. The sections were oxidized in a 0.5% aqueous periodic acid (Sigma-Aldrich, St. Louis, MO, USA) solution for 1 h (room temperature), washed in running water (10 min), and then rinsed with distilled water. The slides were placed in Schiff’s reagent (Sigma-Aldrich, St. Louis, MO, USA) (15 min) in darkness, rinsed with distilled water, and transferred to a 0.5% sodium sulfite solution (2 min). After washing with running tap water (10 min), sections were placed in a 0.5% Toluidine Blue 0 aqueous solution (5 s) to visualize the meristematic cells. The sections were dehydrated in an ethanol series (20% and 40% ethanol for 2 min, 60%, 80%, and 100% for 3 min). For another method, the sections were stained with 0.1% (w/v) methyl blue (Sigma-Aldrich, St. Louis, MO, USA) in a 0.15 M K2HPO4 solution (10 min), rinsed three times with distilled water. They were then incubated in 0.01% Toluidine Blue 0 (in PBS) for 10 min, rinsed with distilled water, and mounted in Fluoromount (Sigma-Aldrich, St. Louis, MO, USA). All observations and photography were done using a Keynote VHX-6000 (Keynote, Mechelen, Belgium) with corresponding software.
Phytohormones concentration measurements
The concentration of phytohormones, including free IAA — free indole-3-acetic acid, IAAox — 2-oxindole-3-acetic acid, JA — jasmonic acid, ABA — abscisic acid, and SA — salicylic acid, was evaluated in the freshly isolated (0 day), and 14 days, 28 days (CIM medium), and 35 days (PRM medium) cultured explants of GP, “Scarlett,” and “Dema.” For analysis, fresh tissue (at least 100 mg) was immediately frozen in liquid nitrogen and stored at −80 °C. Then, they were freeze-dried and ground. The phytohormone concentrations were determined, as described by Li-Marchetti et al. (2015). For each sample, 7 mg of dry powder was extracted with acetone/water/acetic acid (80/19/1). IAA, ABA, SA, and JA stable labeled isotopes used as internal standards were prepared, as described by Le Roux et al. (2014). The experiment was carried out in triplicate.
Analysis of gene expression
Gene expression was analyzed in control and TSA-treated (7.5 μM TSA for 4 weeks on CIM medium) cultures of GP, “Scarlett,” and “Dema.” Total RNA was isolated from cultures induced on the CIM (for 0, 7, 14, 21, and 28 days) and the PRM (for 35 days) medium. To isolate the RNA from the 0 day culture, scutella of IZEs were collected in RNAlater (Life Technologies, Carlsbad, CA, USA) and then treated the same way as the explants that had been cultured on CIM and PRM medium. Total RNA was isolated using a miRVana miRNA Isolation Kit (Thermo Fisher Scientific, Waltham, MA, USA). Depending on the age of the culture, 100 (0 day) to 5 (35 days) explant-derived cultures were used for RNA isolation in one biological replicate. RNA concentrations were measured using a Nano-Drop ND-1000 (NanoDrop Technologies, Wilmington, DE, USA). One microgram of total RNA per sample was treated with RQ1 RNase-Free DNase (Promega Medison, WI, USA) and reverse transcribed in a 20 μl reaction volume using a RevertAid First Strand cDNA Synthesis Kit (Thermo Fisher Scientific, Waltham, MA, USA) with oligo-dT primers, according to the manufacturer’s instructions. The obtained cDNA was diluted fourfold with water and used at a volume of 2.0 μl in a qPCR reaction. Analyses were performed in a 10 μl volume using a LightCycler® 480 SYBR Green I Master (Roche, Basel, Switzerland) in two technical repeats. The primers used in the analyses were designed with Primer3Plus (Supplementary Table 2). The reference gene used in this study was EF1 (elongation factor 1-α; Rapacz et al. 2012). Analyses were performed using a LightCycler 480 (Roche, Basel, Switzerland) under the following reaction conditions: initial denaturation of 5 min at 95 °C, followed by 10 s at 95 °C, 20 s at a temperature specific for the primers, 10 s at 72 °C, repeated in 40 cycles. Denaturation for the melt curve analysis was conducted for 5 s at 95 °C, followed by 1 min at 65 °C and heating to 98 °C (0.1 °C/s for the fluorescence measurement). The Ct values and the value of the qPCR efficiency were obtained from LinRegPCR (version 11, Academic Medical Centre, Amsterdam, The Netherlands). The plant tissues for the real-time qPCR analysis were produced in three biological repetitions. The relative expression level was calculated using 2−∆∆CT, where ∆∆CT represents ∆CTreference condition − ∆CTcompared condition.
Statistical analysis
The two-way ANOVA (p < 0.05) followed by Tukey’s honestly significant difference test (Tukey HSD-test) (p < 0.05) was used to calculate any significant differences between the experimental combinations. The graphs show the average values with the standard deviation (SD).
Results
Plant regeneration efficiency in barley is highly genotype-dependent
The malting cultivars (“Morex,” “Scarlett,” “Krona,” and “Dema”) have significantly lower plant regeneration efficiency than GP
We evaluated the plant regeneration potential of different barley cultivars, including GP, “Morex”, “Scarlett”, “Krona”, and “Dema”, following the culture protocol of Hansel and colleagues (2009). We used the GP cultivar of high plant regenerative potential as a reference genotype. The explants, scutella of IZEs, were induced for 4 weeks on the auxin-rich CIM medium to produce calli. Then, the calli were cultured for the next 4 weeks on the cytokinin-supplemented PRM medium (Fig. 1A–D). The cultures induced on CIM and PRM medium were inspected and sampled along the culture time, and morphogenic processes in callus of different genotypes were analyzed at macroscopic and histological levels. Callus tissue appeared macroscopically on explants in all barley genotypes on the 7th day of CIM culture. White-yellowish callus tissue was produced along the edges of the scutella in place of the embryonic axis that was removed from the explant (Fig. 1E). During the next 3 weeks on the CIM, the callus production increased, and the tissue tended to separate into numerous, small tissue clumps (Fig. 1F). In conclusion, the timing of induction, the dynamic of growth, and the morphology of the callus seemed to be similar in different barley genotypes.
Plant regeneration in barley following the protocol of Hensel et al. (2009) in which scutella of immature zygotic embryos were used as explants. The freshly isolated 0 day explants (A) and explants cultured for 14 days (B), 28 days (C) on the CIM medium, and 56 days (D) on the PRM medium. The timeline represents the culture time points selected for gene expression and hormone concentration analysis. The induction of callus tissue on CIM medium (E, F) and plant regeneration on PRM medium (G, H) in the culture of different barley cultivars: “Golden Promise”, “Dema”, “Scarlett”, “Krona”, and “Morex”. The cultures at 14 (E), 28 (F), 35 (G), 42nd (H), and analysis day — 56 days (I) were shown
In contrast to CIM, which similarly affected different genotypes, differences in timing and efficiency of morphogenic responses between GP and other genotypes were indicated in culture on the PRM. In GP, a 7-day callus induction on the PRM (35 days of culture) resulted in the first patches of greenish tissue, suggesting the induction of the shoot regeneration process (Fig. 1G). Consequently, in the following week (42 days of culture), numerous shoots were produced in the GP culture (Fig. 1H). In contrast to GP, other genotypes showed delayed timing of shoot regeneration. Calluses of “Morex”, “Scarlett”, “Krona”, and “Dema” could produce the first shoots at least 1 week later than GP (Fig. 1H). The 8-week-old cultures were analyzed regarding plant regeneration potential (Fig. 1I).
The effectiveness of callus production on CIM and PRM in different genotypes was quantified. All genotypes were highly effective in callus production, and 100% of explants developed callus. The calli of different genotypes induced on the PRM showed a significantly different capacity for shoot production that was evaluated by the frequency of explants producing at least one shoot (regeneration efficiency, Fig. 2A) and the average number of shoots produced per regenerated explant (regeneration productivity, Fig. 2B). The results indicated the highest plant regeneration potential of the GP culture, and 65% of the GP explants regenerated shoots with over 1.9 productivity on average. Explants of other genotypes regenerated shoots with over three to five times lower efficiency ranging from 12% (“Scarlett”) to 18% (“Morex”). These genotypes also showed lower than GP plant regeneration productivity, and their explants produced 0.6–1.3 shoots per explant.
Plant regeneration potential of different barley cultivars: “Golden Promise”, “Scarlett”, “Krona”, “Dema”, and “Morex”. Plant regeneration efficiency (A) and productivity (B) of culture. * — values significantly different from “Golden Promise” (p < 0.05; n = 3; means ± SD are given). Histological analysis of the “Golden Promise” culture: somatic embryos at 35 days of culture (C) and regeneration of shoots (D) and roots (E) at 42 days of culture. Different types of structures were marked: SAM (shoot apical meristem), LB (leaf bud), v (vascular bundle), and RAM (root apical meristem). The sections were stained with methyl and toluidine blue (C, D) and PAS (E)
To identify the morphogenic pathways involved in the regeneration of barley plants on the PRM medium, the GP callus were histologically examined on the 35th and 42nd day of culture (Fig. 2C–E). Callus was stained with PAS to identify callose in cell walls which marks newly formed cells, including those with embryogenic potential (Dubois et al. 1991). In addition, aniline and toluidine blue staining were used to identify meristematic/embryogenic callus cells with the potential for plant regeneration (O’Brien et al. 1964).
The histological examination provided evidence that the regeneration of barley plants in the GP explants might proceed through two alternative pathways, SE and shoot organogenesis (ORG) (Fig. 2C–E). Accordingly, the bipolar embryo-like structures with shoot apical meristem and a root pole were found in the 35-day-old culture (Fig. 2C). These structures were not connected to the explant through vascular tissue, and this supported an assumption about their embryo-like feature. Besides bi-, unipolar structures connected with the explants and resembling shoot meristems with leaf buds and root meristems were found in 42 days culture (Fig. 2D,E). These structures implied a shoot and root ORG process to be induced in barley calli.
In summary, the barley genotypes showed a high capacity of explants for callus production. However, the capacity of calli for shoot regeneration was highly genotype-dependent. Most of the cultivars, including “Morex”, “Scarlett”, “Krona”, and “Dema”, indicated much lower effectiveness for shoot regeneration than the GP model cultivar. Thus, genetic/epigenetic differences in controlling plant regeneration in barley are assumed.
The genes controlling plant regeneration show distinctly different expressions in GP vs. other genotypes
We inquired whether different plant regeneration capacities of the barley genotypes may be related to differences in the expression of genes controlling plant regeneration. We profiled the expression of analyzed genes encoding TFs such as LEC1, FUS3, BBM, PHB, and ERF022 of regulatory roles in plant regeneration to verify this assumption. Three barley genotypes that differed in capacity for plant regeneration were involved in gene expression profiling, including GP of efficient plant regeneration and poorly regenerating genotypes “Scarlett” and “Dema.”
The expression level of genes was analyzed at different time points of explant culture and compared to that in 0 day explants (Fig. 3). All genotypes showed significantly modulated expression of the genes, including LEC1, FUS3, BBM, PHB, and ERF022, during the culture. The increase and decrease in the gene expression were indicated to be gene- and genotype-dependent. Some similarities in gene expression patterns in different genotypes might be noticed. For example, we noted that the explant induction on the CIM medium decreased the expression of LEC1 and FUS3 and increased BBM transcription in the early culture (7 days) in all analyzed genotypes.
Expression pattern of plant regeneration-related TF genes, including LEC1 (A), FUS3 (B), BBM (C), PHB (D), and ERF022 (E), in the barley cultures of different plant regeneration potential, including “Golden Promise” of high regeneration potential and two genotypes poorly responding in vitro, “Scarlett” and “Dema”. * — values significantly different from 0 day of GP (p < 0.05; n = 3; means ± SD are given); ** — values significantly different from 0 day of “Scarlett” (p < 0.05; n = 3; means ± SD are given); # — values significantly different from 0 day of “Dema” (p < 0.05; n = 3; means ± SD are given)
The pattern of ERF022 expression in the culture of “Dema” and “Scarlett” showed some similarity to that in GP in most of the analyzed culture time points (Fig. 3E). In contrast, the PHB gene revealed a specific pattern of expression in GP culture. The level of PHB transcript was similar to 0 day explants over the “Scarlett” and “Dema” cultures course, while it was significantly modulated in GP (Fig. 3D).
To get better insight into the relationship between plant regeneration capacity and TF gene expression, “Scarlett” and “Dema” transcript levels were compared to those indicated on the relevant day of GP culture with high plant regeneration capacity. The analysis showed a significantly higher expression level (from 1.5 to 30 times) of all genes (FUS3, LEC1, BBM, ERF022, PHB) in plant regeneration recalcitrant genotypes of “Dema” and “Scarlett” than in the GP culture (Fig. 4). Similar to the cultured explants, also the freshly isolated explants (0 day) of “Dema” and “Scarlett” showed a significantly higher (from two to 16 times) than GP accumulation of transcripts of all genes except for LEC1. Thus, over-optimal expression levels of genes controlling plant morphogenesis in vitro might be related to a low regeneration potential of in vitro recalcitrant barley genotypes, “Dema” and “Scarlett”.
The expression level of TF genes LEC1 (A), FUS3 (B), BBM (C), PHB (D), and ERF022 (E) in poorly responding in vitro genotypes of “Scarlett” and “Dema” in relevance to “Golden Promise” of high regeneration potential. The expression level of genes in “Scarlett” and “Dema” cultures was calibrated to expression in GP culture at the same age. * — values significantly different from “Golden Promise” at the same time point (p < 0.05; n = 3; means ± SD are given)
Concluding, barley cultures of different genotypes showed differential expression of plant regeneration-related TF genes, including LEC1, FUS3, BBM, PHB, and ERF022. Noteworthy, a higher level of TF transcripts in freshly isolated and cultured explants was characteristic of poorly plant-regenerated genotypes (“Dema” and “Scarlett”) compared to GP.
Barley genotypes differ in the content of phytohormones in both explants and explant-derived cultures
The content of auxin (free IAA) and its primary catabolite (IAAox), together with stress phytohormones (ABA, JA, and SA), were evaluated in barley cultures of different genotypes. Phytohormones were quantified in the freshly isolated (0 day) and in vitro cultured for 14, 28, and 35 days explants of GP, “Scarlett”, and “Dema” (Fig. 5A–E).
Accumulation of different hormones (ng/gDW), including free-IAA (A), IAAox (B), ABA (C), JA (D), and SA (E) in freshly isolated (0 day) in vitro and cultured barley explants on CIM medium (14 days, 28 days) and PRM medium (35 days) of different genotypes: “Golden Promise”, “Scarlett”, and “Dema”. DW, dry weight. * — values significantly different from 0 day explants of the same genotype (p < 0.05; n = 3; means ± SD are given); # — values significantly different from the “Golden Promise” at the same culture time point (p < 0.05; n = 3; means ± SD are given)
The results showed that a common response of all genotypes to in vitro culture conditions was a rapid and significant decrease of auxin (free IAA), its catabolite IAAox, and two of the stress hormones, JA and ABA, in the cultured explants (Fig. 5A–D). The results also indicated that the primary (0 day) and cultured explants of poorly regenerating genotypes of “Dema” and “Scarlett” significantly differed from GP explants in the content of free IAA. Accordingly, the freshly isolated explants of “Scarlett” accumulated up to 1.4 times more free IAA than the GP explants. In contrast, 0 day explants of “Dema” contained a distinctly lower (1.9 times) than GP level of free IAA. In cultured explants, the difference in accumulation of IAA was strongly pronounced in “Dema” compared to GP. The specific response of “Dema” explants was a lack of free IAA on the CIM medium and the accumulation of IAAox catabolite in explants induced on both CIM and PRM. In “Scarlett”, a level of free IAA on the CIM medium was similar to GP, while explant transfer onto PRM medium (35 days) resulted in elevated over GP accumulation of auxin.
Besides auxin, levels of stress hormones showed distinct differences between genotypes. Compared to GP, the primary explants (0 day) of “Scarlett” contained more ABA (1.6 times) and JA (two times), while in “Dema”, the level of ABA was lower (2.5 times). Genotype-dependent differences in stress hormone levels were also found in explants cultured on CIM and PRM media. For example, in “Dema” culture, the content of JA was lower (over three times), while ABA accumulation was higher (from 1.2 to 3.9 times) than in the GP culture.
We found that the content of auxin and stress-phytohormones (ABA, JA, and SA) both in primary and in vitro cultured explants significantly differed between barley genotypes suggesting that genotype-specific control of phytohormones accumulation might contribute to a strong effect of genotype on plant regeneration in barley. Regardless of genotype, a common response of explants to culture media was a substantial decline in IAA, ABA, and JA content.
TSA treatment improves the regeneration potential in some barley genotypes
To evaluate the effect of TSA on plant regeneration in barley, the explants of five barley genotypes were cultured on a CIM supplemented with different (0.0, 1.0, 2.5, 5.0, and 7.5 μM) TSA concentrations. TSA treatment significantly increased plant regeneration effectiveness (both efficiency and productivity) in two out of five treated barley genotypes. Accordingly, the explants of “Krona” and “Scarlett” treated with 7.5 μM of TSA showed up to two times higher efficiency and productivity of plant regeneration (Fig. 6). Interestingly, explant treatment with 7.5 μM of TSA for 1, 2, and 4 weeks similarly affected plant regeneration. This result might suggest a central role of histone acetylation in regulating plant regeneration-related genes at the very early stage of culture when transcriptomic reprogramming of somatic explant cells is induced.
Effect of TSA treatment on plant regeneration in different barley cultivars: “Golden Promise,” “Krona,” “Scarlett,” “Dema,” and “Morex.” Plant regeneration efficiency and productivity evaluated in barley cultures treated with 0.0, 1.0, 2.5, 5.0, and 7.5 μM of TSA for different times (1, 2, and 4 weeks) in different barley genotypes: “Golden Promise” (A), “Krona” (B), “Scarlett” (C), “Dema” (D), “Morex” (E). W, weeks. * — values significantly different from the control (untreated with TSA) culture (p < 0.05; n = 3; means ± SD are given)
In contrast to the beneficial effect in “Krona” and “Scarlett”, TSA treatment negatively affected plant regeneration in GP and “Dema”. Accordingly, treatments with 1.0 and 2.5 μM TSA for 4 weeks substantially decreased the plant regeneration potential of these genotypes. In “Morex” culture, TSA treatment resulted in no significant changes in plant regeneration capacity.
The results showed a strongly genotype-dependent effect of TSA treatment on plant regeneration in barley. In two genotypes, “Scarlett” and “Krona” TSA treatment resulted in a higher number of regenerated plants suggesting that modification of the epigenetic status of explant cells with TSA might improve the plant regeneration efficiency in some recalcitrant barley genotypes.
TSA treatment increases the expression of plant regeneration-related genes in the barley culture
Given that TSA might affect plant regeneration via controlling gene expression, we analyzed the effect of TSA treatment on expression levels of the plant regeneration genes in the culture of GP, “Dema”, and “Scarlett.” The results indicated that TSA treatment stimulated expression of all analyzed TF genes (LEC1, FUS3, BBM, PHB, ERF022), and the level of TSA-induced increase of expression varied between genes, genotypes, and tissue culture stages (Fig. 7). The highest stimulation of gene transcription was indicated in GP culture in which most of the genes, including FUS3, BBM, ERF022, and PHB, enhanced the transcription up from 10 to 92 folds, while the maximal transcript stimulation, up to 330 folds, was indicated for LEC1. In “Scarlett” and “Dema” cultures, the stimulatory effect of TSA on the gene expression was less pronounced and ranged from 2 folds for FUS3 to 21 folds for LEC1.
TSA-induced increased expression level of the plant regeneration-related TF genes: LEC1 (A), FUS3 (B), BBM (C), PHB (D), and ERF022 (E) in the culture of barley cultivars: “Golden Promise”, “Scarlett”, and “Dema”. Explants were treated with 7.5 μM of TSA for 4 weeks. The expression level of genes in the TSA-treated culture was calibrated to expression in the untreated (control) culture of the same genotype. * — values significantly different from the control culture (untreated with TSA) of the same genotype at the same time point (p < 0.05; n = 3; means ± SD are given)
Discussion
Diverse capacity for plant regeneration of the barley genotypes
The current challenges in cereal and barley biotechnology involve the identification of the genotype-related determinants of plant regeneration in barley and the development of new experimental approaches that enable the efficient regeneration of plants from transformed tissue of different genotypes (Matres et al. 2021). To this end, we analyzed in vitro responses of different barley genotypes, including GP and four malting barley cultivars, “Dema”, “Scarlett”, “Morex”, and “Krona”. These cultivars originated from different parents (see M&M) and showed a high morphological and physiological diversity between them and in comparison to GP (https://barley.agricrops.org/cultivars/compare; Horvath et al. 2003; Cantalapiedra et al. 2017). Noteworthy, the “Morex” was used to create a mapping population (Rao et al. 2007), and the genome was sequenced (Beier et al. 2017).
The results showed a diverse capacity for plant regeneration among the analyzed barley genotypes. In contrast to GP, which regenerated 1.9 plants per explant with an efficiency of 65%, the malting cultivars indicated much lower efficiency (12–18%) and productivity (0.6–1.3) of plant regeneration. Similar to our results, low plant regeneration productivity in “Scarlett”, “Krona”, and “Morex” cultures was also reported by others where IZEs were induced on different media (Chang et al. 2003; Halámková et al. 2004; Hisano et al. 2016). The poor plant regeneration of malting cultivars corresponds with other studies reporting that the efficiency of plant regeneration in barley ranged from 3 to 33% depending on cultivar and regeneration protocol (Chang et al. 2003; Halámková et al. 2004; Aguado-Santacruz et al. 2011; Gubišová et al. 2012; Ślesak et al. 2013). Rarely, manipulation with media composition, mainly PGRs, might improve the plant regeneration of the culture (Przetakiewicz et al. 2003). Adjusting genotype-specific media composition promoting plant regeneration seems time-consuming, costly, and mostly unsuccessful. Thus, to overcome in vitro barley recalcitrance, identifying genetic and epigenetic factors controlling plant regeneration processes and developing new experimental approaches is of central interest to modern biotechnology of this important crop.
Two alternative morphogenic pathways, SE and shoot ORG, contribute to in vitro regeneration of barley plants
Two alternative morphogenic processes, SE and shoot ORG, contribute to plant regeneration in vitro (Bidabadi and Mohan Jain 2020). Depending on the plant species, explant type, and culture protocol, the regenerants are usually produced in favor of one of these pathways (Alemanno et al. 1996; Li et al. 2013; Bartos et al. 2018; Jung et al. 2021). Detailed histological analysis of barley cultures has rarely been conducted, and mostly somatic embryo-like structure development has been reported in cultures derived from mature and immature barley zygotic embryos (Kachhwaha et al. 1997; Nonohay et al. 1999; Eudes et al. 2003).
The histological analysis of the GP culture revealed that both somatic embryos and shoot meristems were produced in the callus suggesting two alternative pathways, SE and ORG, were involved in the regeneration of barley plants. The contribution of ORG and SE has also been reported in barley cultures derived from mature and IZEs induced on different media (Bouamama et al. 2011; Ślesak et al. 2013). Similarly, in other plants, including monocots (Suzuki and Nakano 2001; Mazri et al. 2018) and dicots (Jach and Przywara 2000; Tomaszewska-Sowa et al. 2017; Liang et al. 2020), shoot induction might accompany somatic embryo development. Simultaneous induction of different morphogenic pathways might suggest at least partial similarity of the regulatory network controlling plant regeneration via ORG and SE.
Genotype-dependent capacity for plant regeneration in barley is associated with differential expression of auxin-related TF genes
The overexpression of SE-related TFs such as BBM, LEC1, LEC2, WUS, and WIND1 stimulated the plant regeneration in different plants, including those in vitro recalcitrant, suggesting a central role of genetic regulators in controlling plant regeneration (Srinivasan et al. 2007; Deng et al. 2009; Iwase et al. 2011; Heidmann et al. 2011; Ikeuchi et al. 2013; Horstmann et al. 2017). Most TF genes controlling plant regeneration were attributed to the metabolism and signaling of plant phytohormones (Salaün et al. 2021). Thus, to get insights into the genotype-dependent capacity for plant regeneration in barley, we analyzed the expression of hormone-related TF genes of an essential function in SE induction in Arabidopsis, including LEC1, BBM, FUS3, ERF022, and PHB (Gaj et al. 2005; Braybrook et al. 2006; Nowak et al. 2015; Wójcik et al. 2017). Besides SE, the role of BBM, LEC1, FUS3, and PHB in ORG suggested common functions of the studied TFs in plant regeneration processes (Horstmann et al. 2017; Tang et al. 2017; Zhang et al. 2017; Ikeda et al. 2020; Raspor et al. 2021).
Three barley genotypes of contrasting capacities for plant regeneration, a highly in vitro potent GP cultivar, and two poorly responding cultivars, “Scarlett” and “Dema”, were chosen for the TF expression analysis. The results indicated the high diversity of TF transcript levels between the genotypes in the explants (0 day) and the derived cultures. Interestingly, the TF expression levels were significantly higher in the “Dema” and “Scarlett” than in the GP culture of efficient plant regeneration. We also found that the expression patterns of analyzed TFs were modulated differently over culture time in barley cultures of different genotypes. However, some similarities in expression patterns of TFs were indicated, including decreased expression of LEC1 and FUS3 and increased BBM transcription in the early barley cultures of different genotypes. Since BBM positively regulates LEC1 and FUS3, the members of LAFL (LEC2, ABI3, FUS3, L1L) genes (Horstman et al. 2017), increased expression of LEC1 and FUS3 was associated with the upregulation of BBM in cultures of different species (Florez et al. 2015; Grzybkowska et al. 2018; Brand et al. 2019; Awada et al. 2023). In contrast, we indicated that in barley cultures, the upregulation of BBM was accompanied by decreased expression of LEC1 and FUS3, suggesting differences in regulatory interactions between these TFs in the genetic network controlling plant regeneration of barley and other species.
The genotype-specific expressions of the LEC1 and BBM in barley cultures were also reported by others (Orłowska et al. 2017; Wen et al. 2020; Kumar et al. 2021; Suo et al. 2021). Moreover, global transcriptomic analyses of barley cultures derived from GP and in vitro recalcitrant genotypes indicated numerous differentially expressed genes (DEGs) that might be related to plant regeneration potential (Suo et al. 2021; Xu et al. 2022). Noteworthy, the DEGs involved transcripts that were up- and down-regulated in GP in relevance to the poorly responding barley genotype (Suo et al. 2021; Xu et al. 2022). Significantly, a top group of DEGs was enriched in genes involved in auxin biosynthesis (YUCCA), signaling (ARFs and Aux/IAAs), and polar auxin transport (PINs), pointing to a central role of auxin in plant regeneration of barley (Suo et al. 2021; Xu et al. 2022). In support of this postulate, BBM, LEC1, and FUS3 TFs that we also found differentially expressed in barley, control auxin-related genes, including YUC, Aux/IAA, ARF, and PIN, and regulate embryogenic induction in Arabidopsis (Yamamoto et al. 2009; Junker et al. 2012; Wang and Perry 2013; Horstmann et al. 2017). These results suggest that BBM, LEC1, and FUS3 can be considered as candidate TFs for further research on auxin-related genetic pathways regulating plant regeneration potential in barley. In Arabidopsis, these TFs interact with LEC2 of the B3 TF gene family, which is essential in auxin-dependent embryogenic transition (Horstmann et al. 2017). Surprisingly, LEC2 has not been identified in the barley genome (databases: EnsemblPlants, Plaza), and that implies some differences in the genetic regulation of auxin-related embryogenic induction in barley and Arabidopsis. These differences might involve the genetic interactions of PHB and ERF022, which in SE of Arabidopsis operate in the LEC2-related pathways (Nowak et al. 2015; Wójcik et al. 2017).
In support of the role of auxin in the genotypic diversity of plant regeneration capacity in barley, we indicated distinct differences in auxin accumulation (free IAA and IAAox) in explants and explant-derived callus cultures of the GP, “Dema”, and “Scarlett”. Similarly, callus cultures of other in vitro recalcitrant barley cultivars (“Haruna Nijo” and “Morex”) accumulated IAA at a level different from the GP culture (Hisano et al. 2016). Although the links between auxin content in explants/callus and the plant regeneration potential were also reported in other plant species (Nic-Can and Loyola-Vargas 2016), in vitro responding genotypes indicated both higher and lower accumulation of IAA than those in vitro recalcitrant (Żur et al. 2015; Hisano et al. 2016; Grzyb et al. 2017; Caeiro et al. 2022).
To control plant development, auxin interacts with other phytohormones, including those related to stress responses, which are essential in in vitro induced plant morphogenesis (Zavattieri et al. 2010; Fehér 2015). Relevantly, numerous stress-related genes, including those related to stress hormones, were differentially expressed in embryogenic cultures of different plants (Legrand et al. 2007; Wickramasuriya and Dunwell 2015), including barley cultures of opposed plant regeneration potential (Xu et al. 2022). Similarly, we indicated different accumulations of ABA, JA, and SA in GP vs. “Dema” and “Scarlett” cultures. The relationship between hormone content and plant regeneration capacity seems to be complex and inconclusive results on phytohormone ratio, including IAA/ABA, favoring plant regeneration were reported in barley (Hisano et al. 2016) and other plants (Centeno et al. 1997; Zhou et al. 2017; Gatica-Arias et al. 2019; Awada et al. 2020). Altogether, the results provide evidence that the genotype-specific control of phytohormones levels might contribute to the diverse capacities of barley cultivars for plant regeneration.
We profiled the expressions of auxin biosynthesis-related genes to get insights into metabolic pathways controlling auxin accumulation in barley cultures. The results indicated HvYUC7/AtYUC10 (Harb et al. 2020) and TAA1 (TRYPTOPHAN AMINOTRANSFERASE OF ARABIDOPSIS 1) genes to be differentially expressed in “Dema” and “Scarlett” in comparison to GP culture (Supplementary Fig. 1). Both genes have a critical role in auxin biosynthesis via the Trp (tryptophan)-dependent IPyA (indole-3-pyruvic acid) pathway in plants, including barley (Pérez-Pérez et al. 2019). The role of TAA1 and different YUC genes, including YUC10, in IAA biosynthesis in plant morphogenesis in vitro was indicated (Bai et al. 2013; Wójcikowska et al. 2013; Raspor et al. 2021). Thus, we assumed that the IPyA pathway might also be involved in auxin biosynthesis associated with the regeneration of barley plants. Further analysis is required to identify the components of the Trp-dependent IPA pathway, including other genes of the eight members of the YUC gene family in barley (Harb et al. 2020) that might be involved in controlling auxin biosynthesis in plant regeneration in this crop.
TSA modifies the expression of genes and improves the plant regeneration potential of poorly responding in vitro barley genotypes
Distinct differences in the expression of TF genes found between the GP and poorly in vitro responding genotypes suggested that modifying gene expression might improve plant regeneration in barley. Following this assumption, we treated the barley explants with TSA, the chromatin modifier which, via inhibition of TSA-sensitive HDACs, changes histone acetylation and gene expression (Görisch et al. 2005).
Our results showed the genotype-specific effect of TSA in barley cultures. The stimulatory effect of the TSA treatment on plant regeneration was indicated in two barley cultivars, “Scarlett” and “Krona”. The genotype-dependent results of TSA treatment were also observed in B. rapa (Zhang et al. 2016) and wheat (Jiang et al. 2017; Bie et al. 2020). Besides genotype, the effect of TSA on plant regeneration depends on treatment conditions such as concentration and treatment time (Castillo et al. 2020; Martínez et al. 2021; Choi et al. 2023). We tested the effect of TSA at a wide range of concentrations (1.0–7.5 μM) and durations of treatment (1, 2, and 4 weeks) and indicated the dose of 7.5 μM of TSA for 4 weeks to be effective in stimulation of plant regeneration in some barley genotypes. In other plants, TSA in the concentration of 0.1–2.5 μM for 10 min–3 weeks was used (Jiang et al. 2017; Wójcikowska et al. 2018; Castillo et al. 2020; Bie et al. 2020). In wheat, depending on genotype, microspores treatment with 0.1 and 0.3 μM of TSA for 10 min was effective in plant regeneration stimulation (Jiang et al. 2017). Altogether, the results indicated a high diversity of plant regeneration-effective TSA doses implying differences between species and genotypes in TSA sensitivity.
We assumed that TSA might affect plant regeneration in barley via stimulation of TF genes controlling plant regeneration. The results on gene expression profiling revealed that regardless of genotype, a common response to TSA treatment was the increase of TF gene transcripts level of LEC1, FUS3, BBM, PHB, and ERF022 genes in barley cultures. Similarly, SE-involved TFs were upregulated in TSA-treated cultures of Arabidopsis (Wójcikowska et al. 2018), P. abies (Uddenberg et al. 2011), and B. napus (Li et al. 2014). Relevantly, the deregulation of a restricted set of genes was commonly reported due to TSA treatment (Lint et al. 1996; Chang and Pikaard 2005; Ma et al. 2016), implying a non-stochastic induction of genes by TSA (Xu et al. 2007). Thus, the analyzed TFs of regulatory function in plant regeneration seem to be specifically responsive to TSA. That implies the substantial role of histone acetylation and the TSA-sensitive HDACs in the genetic mechanism regulating plant regeneration. In support, the involvement of HDA6 and HDA19 in the repression of LEC1, FUS3, and BBM was reported (Tanaka et al. 2008; Jia et al. 2014; Morończyk et al. 2022). Thus, we assumed that the upregulation of TFs in barley cultures resulted from TSA-induced inhibition of the enzymatic activity of HDACs (Wójcikowska et al. 2018).
Besides inhibition of HDACs, TSA might affect cell transcriptome by other processes. For example, TSA might modulate the expression of HDAC genes, including those regulating plant-regeneration TFs. In support, we indicated intensive upregulation of HDA6 and HDA19 expression in response to TSA treatment in barley cultures of different genotypes (Supplementary Fig. 2). Similarly, TSA stimulated the expression of HDACs, including HDA6 in the culture of grapevine (Martínez et al. 2021), Arabidopsis (Morończyk et al. 2022), and wheat (Valero-Rubira et al. 2023). Relevantly, acetylation of histone marks has been indicated in the chromatin associated with the HAT/HDACs genes, including HDA6 (PlantPan 3.0, Chow et al. 2019). Moreover, TSA-induced histone acetylation might impose other epigenetic changes, including histone methylation marks that activate (H3K27me3) and suppress (H3K4me2) gene expression (Pandey et al. 2016; Valero-Rubira et al. 2023). The reports on the diversity of the TSA-imposed epigenetic changes and the present results suggest the complex and genotype-specific effects of TSA on gene expression and plant regeneration.
The study demonstrated that treating barley explants with TSA affects the expression of TFs of regulatory function in plant regeneration and might provide an effective and simple method for improving plant regeneration response in some recalcitrant barley genotypes. Combining TSA treatment with other epigenetic agents, including DNA methylation inhibitor (5-Aza-deoxycytidine), might also be recommended to improve the developmental potential of in vitro recalcitrant species such as barley (Chang and Pikaard 2005; Wang et al. 2011). In conclusion, the wider implementation of epigenetic modifiers in research on in vitro plant regeneration might help to overcome problems hampering the common use of genetic transformation and genome editing in breeding important crop plants, including barley.
References
Abrahamsson M, Valladares S, Merino I et al (2017) Degeneration pattern in somatic embryos of Pinus sylvestris L. In Vitro Cell Dev Biol Plant 53:86–96. https://doi.org/10.1007/s11627-016-9797-y
Aguado-Santacruz GA, Velázquez-Ordinola Á, Moreno-Gómez B et al (2011) Development of long-term and reliable in vitro plant regeneration systems for elite malting barley varieties: optimizing media formulation and explant selection. Afr J Biotechnol 10:19522–19533. https://doi.org/10.5897/AJB11.1736
Alemanno L, Berthouly M, Michaux-Ferribre N (1996) Histology of somatic embryogenesis from floral tissues cocoa. Plant Cell Tissue Organ Cult 46:187–194. https://doi.org/10.1007/BF02307094
Anjanappa RB, Gruissem W (2021) Current progress and challenges in crop genetic transformation. J Plant Physiol 261:1–13 https://doi.org/10.1016/j.jplph.2021.153411
Awada R, Lepelley M, Breton D et al (2023) Global transcriptome profiling reveals differential regulatory, metabolic and hormonal networks during somatic embryogenesis in Coffea arabica. BMC Genom 24:41–60. https://doi.org/10.1186/s12864-022-09098-z
Awada R, Verdier D, Froger S et al (2020) An innovative automated active compound screening system allows high-throughput optimization of somatic embryogenesis in Coffea arabica. Sci Rep 10:810–824. https://doi.org/10.1038/s41598-020-57800-6
Bai B, Su YH, Yuan J, Zhang XS (2013) Induction of somatic embryos in arabidopsis requires local YUCCA expression mediated by the down-regulation of ethylene biosynthesis. Mol Plant 6:1247–1260. https://doi.org/10.1093/mp/sss154
Baik BK, Ullrich SE (2008) Barley for food: characteristics, improvement, and renewed interest. J Cereal Sci 48:233–242. https://doi.org/10.1016/J.JCS.2008.02.002
Bartos PMC, Gomes HT, Gomes SM et al (2018) Histology of somatic embryogenesis in Coffea arabica L. Biologia (Bratisl) 73:1255–1265. https://doi.org/10.2478/s11756-018-0131-5
Beier S, Himmelbach A, Colmsee C et al (2017) Construction of a map-based reference genome sequence for barley, Hordeum vulgare L. Sci Data 4. https://doi.org/10.1038/sdata.2017.44
Belide S, Zhou XR, Kennedy Y et al (2013) Rapid expression and validation of seed-specific constructs in transgenic LEC2 induced somatic embryos of Brassica napus. Plant Cell Tissue Organ Cult 113:543–553. https://doi.org/10.1007/s11240-013-0295-1
Bidabadi SS, Mohan Jain S (2020) Cellular, molecular, and physiological aspects of in vitro plant regeneration. Plants 9:702–722
Bie XM, Dong L, Li XH et al (2020) Trichostatin A and sodium butyrate promotes plant regeneration in common wheat. Plant Signal Behav 15:1820681. https://doi.org/10.1080/15592324.2020.1820681
Bouamama B, Ben SA, Ben YF et al (2011) Somatic embryogenesis and organogenesis from mature caryopses of North African barley accession “Kerkena” (Hordeum vulgare L.). In Vitro Cell Dev Biol Plant 47:321–327. https://doi.org/10.1007/s11627-011-9357-4
Boutilier K, Offringa R, Sharma VK et al (2002) Ectopic expression of BABY BOOM triggers a conversion from vegetative to embryonic growth. Plant Cell 14:1737–1749. https://doi.org/10.1105/tpc.001941.tissue
Brand A, Quimbaya M, Tohme J, Chavarriaga-Aguirre P (2019) Arabidopsis LEC1 and LEC2 orthologous genes are key regulators of somatic embryogenesis in cassava. Front Plant Sci 10. https://doi.org/10.3389/fpls.2019.00673
Braybrook SA, Stone SL, Park S et al (2006) Genes directly regulated by LEAFY COTYLEDON2 provide insight into the control of embryo maturation and somatic embryogenesis. PNAS 103:3468–3473. https://doi.org/10.1073/pnas.0511331103
Bykova IV, Lashina NM, Efimov VM et al (2017) Identification of 50 K Illumina-chip SNPs associated with resistance to spot blotch in barley. BMC Plant Biol 17. https://doi.org/10.1186/s12870-017-1198-9
Caeiro A, Caeiro S, Correia S, Canhoto J (2022) Induction of somatic embryogenesis in Tamarillo (Solanum betaceum Cav.) involves increases the endogenous auxin indole-3-acetic acid. Plants 11:1374–1391. https://doi.org/10.3390/plants11101347
Cantalapiedra CP, García-Pereira MJ, Gracia MP et al (2017) Large differences in gene expression responses to drought and heat stress between elite barley cultivar scarlett and a Spanish landrace. Front Plant Sci 8:647–670. https://doi.org/10.3389/fpls.2017.00647
Castillo AM, Valero-Rubira I, Burrell MÁ et al (2020) Trichostatin a affects developmental reprogramming of bread wheat microspores towards n embryogenic route. Plants 9:1–22. https://doi.org/10.3390/plants9111442
Centeno ML, Rodriguez R, Berros B, Rodriguez A (1997) Endogenous hormonal content and somatic embryogenic capacity of Corylus avellana L. cotyledons. Plant Cell Rep 17:139–144
Chang S, Pikaard CS (2005) Transcript profiling in Arabidopsis reveals complex responses to global inhibition of DNA methylation and histone deacetylation. J Biol Chem 280:796–804. https://doi.org/10.1074/jbc.M409053200
Chang Y, Von Zitzewitz J, Hayes PM, Chen THH (2003) High frequency plant regeneration from immature embryos of an elite barley cultivar (Hordeum vulgare L. cv. Morex). Plant Cell Rep 21:733–738. https://doi.org/10.1007/s00299-003-0607-8
Chauhan M, Kothari SL (2004) Optimization of nutrient levels in the medium increases the efficiency of callus induction and plant regeneration in recalcitrant Indian barley (Hordeum vulgare L.) in vitro. In Vitro Cell Dev Biol Plant 40:520–527. https://doi.org/10.1079/IVP2004565
Choi SH, Ahn WS, Lee MH et al (2023) Effects of TSA, NaB, Aza in Lactuca sativa L. protoplasts and effect of TSA in Nicotiana benthamiana protoplasts on cell division and callus formation. PLoS One 18:e0279627. https://doi.org/10.1371/journal.pone.0279627
Chow CN, Lee TY, Hung YC et al (2019) Plantpan3.0: a new and updated resource for reconstructing transcriptional regulatory networks from chip-seq experiments in plants. Nucleic Acids Res 47:1155–1163. https://doi.org/10.1093/nar/gky1081
Dahleen LS, Bregitzer P (2002) An improved media system for high regeneration rates from barley immature embryo-derived callus cultures of commercial cultivars. Crop Sci 42:934–938. https://doi.org/10.2135/cropsci2002.9340
Dawson IK, Russell J, Powell W et al (2015) Barley: a translational model for adaptation to climate change. New Phytol 206:913–931
Debernardi JM, Tricoli DM, Ercoli MF et al (2020) A GRF–GIF chimeric protein improves the regeneration efficiency of transgenic plants. Nat Biotechnol 38:1274–1279. https://doi.org/10.1038/s41587-020-0703-0
Deng W, Luo K, Li Z, Yang Y (2009) A novel method for induction of plant regeneration via somatic embryogenesis. Plant Sci 177:43–48. https://doi.org/10.1016/j.plantsci.2009.03.009
Douchkov D, Lück S, Johrde A et al (2014) Discovery of genes affecting resistance of barley to adapted and non-adapted powdery mildew fungi. Genome Biol 15:518. https://doi.org/10.1186/s13059-014-0518-8
Dubois T, Guedira M, Dubois J, Vasseur J (1991) Direct somatic embryogenesis in leaves of Cichorimn A histological and SEM study of early stages. Protoplasma 162:120–127. https://doi.org/10.1007/BF02562555
Eudes F, Acharya S, Laroche A et al (2003) A novel method to induce direct somatic embryogenesis, secondary embryogenesis and regeneration of fertile green cereal plants. Plant Cell Tissue Organ Cult 73:147–157. https://doi.org/10.1007/s11627-001-0067-1
Fehér A (2015) Somatic embryogenesis — stress-induced remodeling of plant cell fate. Biochim Biophys Acta Gene Regul Mech 1849:385–402. https://doi.org/10.1016/j.bbagrm.2014.07.005
Florez SL, Erwin RL, Maximova SN et al (2015) Enhanced somatic embryogenesis in Theobroma cacao using the homologous BABY BOOM transcription factor. BMC Plant Biol 15:121–134. https://doi.org/10.1186/s12870-015-0479-4
Furumai R, Komatsu Y, Nishino N et al (2001) Potent histone deacetylase inhibitors built from trichostatin A and cyclic tetrapeptide antibiotics including trapoxin. PNAS 98:87–92
Gaj MD, Zhang S, Harada JJ, Lemaux PG (2005) Leafy cotyledon genes are essential for induction of somatic embryogenesis of Arabidopsis. Planta 222:977–988. https://doi.org/10.1007/s00425-005-0041-y
Ganeshan S, Weir BJ, Båga M et al (2006) Evaluation of the enhanced regeneration system for in vitro regeneration in barley. Can J Plant Sci 86:63–69. https://doi.org/10.4141/P05-055
Gatica-Arias A, Vargas-Corrales K, Benavides-Acevedo M et al (2019) Morphological and biochemical changes during somatic embryogenesis in mahogany, Swietenia macrophylla (Meliaceae). Rev Biol Trop 67:406–418
Gliwicka M, Nowak K, Balazadeh S et al (2013) Extensive modulation of the transcription factor transcriptome during somatic embryogenesis in Arabidopsis thaliana. PLoS One 8:e69261. https://doi.org/10.1371/journal.pone.0069261
Görisch SM, Wachsmuth M, Tóth KF et al (2005) Histone acetylation increases chromatin accessibility. J Cell Sci 118:5825–5834. https://doi.org/10.1242/jcs.02689
Grzyb M, Kalandyk A, Waligórski P, Mikuła A (2017) The content of endogenous hormones and sugars in the process of early somatic embryogenesis in the tree fern Cyathea delgadii Sternb. Plant Cell Tissue Organ Cult 129:387–397. https://doi.org/10.1007/s11240-017-1185-8
Grzybkowska D, Morończyk J, Wójcikowska B, Gaj MD (2018) Azacitidine (5-AzaC)-treatment and mutations in DNA methylase genes affect embryogenic response and expression of the genes that are involved in somatic embryogenesis in Arabidopsis. Plant Growth Regul 85:243–256. https://doi.org/10.1007/s10725-018-0389-1
Gubišová M, Mihálik D, Gubiš J, Gubišová M (2012) Optimization of barley mature embryo regeneration and comparison with immature embryos of local cultivars. Nova Biotechnologica et Chimica 11:57–62. https://doi.org/10.2478/v10296-012-0006-z
Guo F, Liu C, Xia H et al (2013) Induced expression of AtLEC1 and AtLEC2 differentially promotes somatic embryogenesis in transgenic tobacco plants. PLoS One 8. https://doi.org/10.1371/journal.pone.0071714
Halámková E, Vagera J, Ohnoutková L (2004) Regeneration capacity of calli derived from immature embryos in spring barley cultivars. Biol Plant 48:313–316. https://doi.org/10.1023/B:BIOP.0000033464.36078.24
Harb AM, Al-Hadid KJ, Sharab AS (2020) Molecular and biochemical changes of indole-3-acetic acid in the expanding leaves of barley (Hordeum vulgare L.) under salinity stress. Jordan J Biol Sci 13:93–100
Harding EW, Tang W, Nichols KW et al (2003) Expression and maintenance of embryogenic potential is enhanced through constitutive expression of AGAMOUS-like 15. Plant Physiol 133:653–663. https://doi.org/10.1104/pp.103.023499
Harwood WA (2012) Advances and remaining challenges in the transformation of barley and wheat. J Exp Bot 63:1791–1798. https://doi.org/10.1093/jxb/err380
Hayta S, Smedley MA, Demir SU et al (2019) An efficient and reproducible Agrobacterium-mediated transformation method for hexaploid wheat (Triticum aestivum L.). Plant Methods 15. https://doi.org/10.1186/s13007-019-0503-z
Heidmann I, de Lange B, Lambalk J et al (2011) Efficient sweet pepper transformation mediated by the BABY BOOM transcription factor. Plant Cell Rep 30:1107–1115. https://doi.org/10.1007/s00299-011-1018-x
Hensel G, Kastner C, Oleszczuk S et al (2009) Agrobacterium-mediated gene transfer to cereal crop plants: current protocols for barley, wheat, triticale, and maize. Int J Plant Genomics 2009:1–9. https://doi.org/10.1155/2009/835608
Hisano H, Matsuura T, Mori IC et al (2016) Endogenous hormone levels affect the regeneration ability of callus derived from different organs in barley. Plant Physiol Biochem 99:66–72. https://doi.org/10.1016/j.plaphy.2015.12.005
Horstman A, Li M, Heidmann I et al (2017) The BABY BOOM transcription factor activates the LEC1-ABI3-FUS3-LEC2 network to induce somatic embryogenesis. Plant Physiol 175:848–857. https://doi.org/10.1104/pp.17.00232
Horstmann A, Bemer M, Boutilier K (2017) A transcriptional view on somatic embryogenesis. Regeneration 4:201–216
Horvath H, Rostoks N, Brueggeman R et al (2003) Genetically engineered stem rust resistance in barley using the Rpg1 gene. PNAS 100:364–369
Ikeda M, Takahashi M, Fujiwara S et al (2020) Improving the efficiency of adventitious shoot induction and somatic embryogenesis via modification of WUSCHEL and LEAFY COTYLEDON1. Plants 9:1–11. https://doi.org/10.3390/plants9111434
Ikeuchi M, Sugimoto K, Iwase A (2013) Plant callus: mechanisms of induction and repression. Plant Cell 25:3159–3173
Iwase A, Mitsuda N, Koyama T et al (2011) The AP2/ERF transcription factor WIND1 controls cell dedifferentiation in Arabidopsis. Curr Biol 21:508–514. https://doi.org/10.1016/j.cub.2011.02.020
Jabbari M, Fakheri BA, Aghnoum R et al (2018) GWAS analysis in spring barley (Hordeum vulgare L.) for morphological traits exposed to drought. PLoS One 13. https://doi.org/10.1371/journal.pone.0204952
Jach M, Przywara L (2000) Somatic embryogenesis and organogenesis induced in immature zygotic embryos of selected sunflower (Helianthus annuus L. ) genotypes. Acta Biol Cracov Ser Bot 42:83–86
Jia H, Suzuki M, McCarty R (2014) Regulation of the seed to seedling developmental phase transition by the LAFL and VAL factor networks. Wiley Interdiscip Rev Dev Biol 3:135–145
Jiang F, Ryabova D, Diedhiou J et al (2017) Trichostatin A increases embryo and green plant regeneration in wheat. Plant Cell Rep 36:1701–1706. https://doi.org/10.1007/s00299-017-2183-3
Jung W-S, Chung I-M, Kim S-H et al (2021) Direct shoot organogenesis from Lycium chinense Miller leaf explants and assessment of genetic stability using ISSR markers. Agronomy 11:503–519. https://doi.org/10.3390/agronomy
Junker A, Monke G, Rutten T et al (2012) Elongation-related functions of LEAFY COTYLEDON1 during the development of Arabidopsis thaliana. Plant J 71:427–442. https://doi.org/10.1111/j.1365-313X.2012.04999.x
Kachhwaha S, Varshney A, Kothari SL (1997) Somatic embryogenesis and long term high plant regeneratio from barley (Hordeum vulgare L.) using Picloram. Cereal Res Commun 25:117–126. https://doi.org/10.1007/BF03543446
Kumar S, Ruggles A, Logan S et al (2021) Comparative transcriptomics of non-embryogenic and embryogenic callus in semi-recalcitrant and non-recalcitrant upland cotton lines. Plants 10:1775–1791. https://doi.org/10.3390/plants10091775
Lardon R, Wijnker E, Keurentjes J, Geelen D (2020) The genetic framework of shoot regeneration in Arabidopsis comprises master regulators and conditional fine-tuning factors. Commun Biol 3. https://doi.org/10.1038/s42003-020-01274-9
Le Roux C, Del Prete S, Boutet-Mercey S et al (2014) The hnRNP-Q protein LIF2 participates in the plant immune response. PLoS One 9:e99343. https://doi.org/10.1371/journal.pone.0099343
Lee K, Wang K (2023) Strategies for genotype-flexible plant transformation. Curr Opin Biotechnol 79. https://doi.org/10.1016/j.copbio.2022.102848
Legrand S, Hendriks T, Hilbert J-L, Quillet M-C (2007) Characterization of expressed sequence tags obtained by SSH during somatic embryogenesis in Cichorium intybus L. BMC Plant Biol 7:27–39. https://doi.org/10.1186/1471-2229-7-27
Li H, Soriano M, Cordewener J et al (2014) The histone deacetylase inhibitor trichostatin A promotes totipotency in the male gametophyte. Plant Cell 26:195–209. https://doi.org/10.1105/tpc.113.116491
Li Q, Deng M, Zhang J et al (2013) Shoot Organogenesis and Plant Regeneration from Leaf Explants of Lysionotus serratus D. Don. Sci World J 2013:280384. https://doi.org/10.1155/2013/280384
Liang H, Xiong Y, Guo B et al (2020) Shoot organogenesis and somatic embryogenesis from leaf and root explants of Scaevola sericea. Sci Rep 10:11343. https://doi.org/10.1038/s41598-020-68084-1
Li-Marchetti CL, Le BC, Relion D et al (2015) Genotypic differences in architectural and physiological responses to water restriction in rose bush. Front Plant Sci 6:1–14. https://doi.org/10.3389/fpls.2015.00355
Lint CV, Emiliani S, Ott M, Verdin E (1996) Transcriptional activation and chromatin remodeling of the HIV-1 promoter in response to histone acetylation. EMBO J 15:1112–1120
Lotan T, Ohto MA, Matsudaira Yee K et al (1998) Arabidopsis LEAFY COTYLEDON1 is sufficient to induce embryo development in vegetative cells. Cell 93:1195–1205. https://doi.org/10.1016/s0092-8674(00)81463-4
Lü B, Wu JJ, Fu DL (2015) Constructing the barley model for genetic transformation in Triticeae. J Integr Agric 14:453–468
Ma X, Zhang C, Zhang B et al (2016) Identification of genes regulated by histone acetylation during root development in Populus trichocarpa. BMC Genom 17:96–114. https://doi.org/10.1186/s12864-016-2407-x
Marthe C, Kumlehn J, Hensel G (2015) Barley (Hordeum vulgare L.) transformation using immature embryos. Methods Mol Biol 1223:71–83. https://doi.org/10.1007/978-1-4939-1695-5_6
Martínez Ó, Arjones V, González MV, Rey M (2021) Histone deacetylase inhibitors increase the embryogenic potential and alter the expression of embryogenesis-related and hdac-encoding genes in grapevine (Vitis vinifera l., cv. mencía). Plants 10:1164–1183. https://doi.org/10.3390/plants10061164
Matres JM, Hilscher J, Datta A et al (2021) Genome editing in cereal crops: an overview. Transgenic Res 30:461–498
Mazri MA, Meziani R, Belkoura I et al (2018) A combined pathway of organogenesis and somatic embryogenesis for an efficient large-scale propagation in date palm (Phoenix dactylifera L.) cv. Mejhoul. 3 Biotech 8:215–223. https://doi.org/10.1007/s13205-018-1235-x
Morończyk J, Braszewska A, Wójcikowska B et al (2022) Insights into the histone acetylation-mediated regulation of the transcription factor genes that control the embryogenic transition in the somatic cells of Arabidopsis. Cells 11:863. https://doi.org/10.3390/cells11050863
Nadolska-Orczyk A, Przetakiewicz A, Wacław O (2000) Transformacja genetyczna zbóż za pomocą Agrobacterium. Biotechnologia 4:93–98
Nic-Can GI, Loyola-Vargas VM (2016) The role of the auxins during somatic embryogenesis. In: Somatic embryogenesis: fundamental aspects and applications. Springer International Publishing, pp 171–182
Nonohay JS, Mariath JEA, Winge H (1999) Histological analysis of somatic embryogenesis in Brazilian cultivars of barley, Hordeum vulgare vulgare, Poaceae. Plant Cell Rep 18:929–934. https://doi.org/10.1007/s002990050686
Nowak K, Wójcikowska B, Gaj MD (2015) ERF022 impacts the induction of somatic embryogenesis in Arabidopsis through the ethylene-related pathway. Planta 241:967–985. https://doi.org/10.1007/s00425-014-2225-9
O’Brien TP, Feder N, McCully ME (1964) Polychromatic staining of plant cell walls by toluidine blue O. Protoplasma 59:368–373. https://doi.org/10.1007/BF01248568
Orłowska A, Igielski R, Łagowska K, Kępczyńska E (2017) Identification of LEC1, L1L and polycomb repressive complex 2 genes and their expression during the induction phase of Medicago truncatula Gaertn. somatic embryogenesis. Plant Cell Tissue Organ Cult 129:119–132. https://doi.org/10.1007/s11240-016-1161-8
Orman-Ligeza B, Harwood W, Hedley PE et al (2020) TRA1: a locus responsible for controlling Agrobacterium-mediated transformability in barley. Front Plant Sci 11. https://doi.org/10.3389/fpls.2020.00355
Pandey G, Sharma N, Sahu PP, Prasad M (2016) Chromatin-based epigenetic regulation of plant abiotic stress response. Curr Genomics 17:490–498. https://doi.org/10.2174/1389202917666160520103914
Pérez-Pérez Y, El-Tantawy AA, Solís MT et al (2019) Stress-induced microspore embryogenesis requires endogenous auxin synthesis and polar transport in barley. Front Plant Sci 10:1200–1216. https://doi.org/10.3389/fpls.2019.01200
Przetakiewicz A, Orczyk W, Nadolska-Orczyk A (2003) The effect of auxin on plant regeneration of wheat, barley and triticale. Plant Cell Tissue Organ Cult 73:245–256. https://doi.org/10.1023/A:1023030511800
Rao HS, Basha OP, Singh NK et al (2007) Frequency distributions and composite interval mapping for QTL analysis in “Steptoe” x “Morex” barley mapping population. Barley Genet Newsl 37:5–20
Rapacz M, Stępień A, Skorupa K (2012) Internal standards for quantitative RT-PCR studies of gene expression under drought treatment in barley (Hordeum vulgare L.): the effects of developmental stage and leaf age. Acta Physiol Plant 34:1723–1733. https://doi.org/10.1007/s11738-012-0967-1
Raspor M, Motyka V, Kaleri AR et al (2021) Integrating the roles for cytokinin and auxin in de novo shoot organogenesis: from hormone uptake to signaling outputs. Int J Mol Sci 22:8554
Russell J, Fuller J, Young G et al (1997) Discriminating between barley genotypes using microsatellite markers. Genome 40:442–450. https://doi.org/10.1139/g97-059
Saisho D, Takeda K (2011) Barley: emergence as a new research material of crop science. Plant Cell Physiol 52:724–727
Salaün C, Lepiniec L, Dubreucq B (2021) Genetic and molecular control of somatic embryogenesis. Plants 10. https://doi.org/10.3390/plants10071467
Senarath WTPSK (2007) High frequency plant regeneration from immature embryos of an elite barley cultivar (Hordeum vulgare L cv Baegdong). J NatnSciFoundation Sri Lanka 35:161–165. https://doi.org/10.4038/jnsfsr.v35i3.2014
Serhantova V, Ehrenbergerova J, Ohnoutkova L (2004) Callus induction and regeneration efficiency of spring barley cultivars registered in Czech Republic. Plant Soil Environ 50:456–462
Seto E, Yoshida M (2014) Erasers of histone acetylation: the histone deacetylase enzymes. Cold Spring Harb Perspect Biol 6. https://doi.org/10.1101/cshperspect.a018713
Shin J, Bae S, Seo PJ (2020) De novo shoot organogenesis during plant regeneration. J Exp Bot 71:63–72
Ślesak H, Góralski G, Pawłowska H et al (2013) The effect of genotype on a barley scutella culture. Histological aspects Cent Eur J Biol 8:30–37. https://doi.org/10.2478/s11535-012-0113-5
Srinivasan C, Liu Z, Heidmann I et al (2007) Heterologous expression of the BABY BOOM AP2/ERF transcription factor enhances the regeneration capacity of tabacoo (Nicotiana tabacum L.). Planta 225:341–351
Suo J, Zhou C, Zeng Z et al (2021) Identification of regulatory factors promoting embryogenic callus formation in barley through transcriptome analysis. BMC Plant Biol 21. https://doi.org/10.1186/s12870-021-02922-w
Suzuki S, Nakano M (2001) Organogenesis and somatic embryogenesis from callus cultures of Muscari armeniacum Leichlt.. Ex Bak. In Vitro Cell Dev Biol 37:302–307. https://doi.org/10.1007/s11627-001-0067-1
Tanaka M, Kikuchi A, Kamada H (2008) The arabidopsis histone deacetylases HDA6 and HDA19 contribute to the repression of embryonic properties after germination. Plant Physiol 146:149–161. https://doi.org/10.1104/pp.107.111674
Tang LP, Zhou C, Wang SS et al (2017) FUSCA3 interacting with LEAFY COTYLEDON2 controls lateral root formation through regulating YUCCA4 gene expression in Arabidopsis thaliana. New Phytol 213:1740–1754. https://doi.org/10.1111/nph.14313
Teklemariam SS, Bayissa KN, Matros A et al (2022) The genetic diversity of Ethiopian barley genotypes in relation to their geographical origin. PLoS One 17. https://doi.org/10.1371/journal.pone.0260422
Tomaszewska-Sowa M, Figas A, Gatz A, Gatz Katedra Genetyki A (2017) Histological analysis of organogenesis and somatic embryogenesis during shoot formation in sugar beet (Beta vulgaris L.) via gynogenesis. Pol J Natur Sc 32:705–117
Tsuji N, Kobayashi M, Nagashima K et al (1976) A new antifungal antibiotic, trichostatin. J Antibiot (Tokyo) 29:1–6. https://doi.org/10.7164/antibiotics.29.1
Tsuwamoto R, Yokoi S, Takahata Y (2010) Arabidopsis EMBRYOMAKER encoding an AP2 domain transcription factor plays a key role in developmental change from vegetative to embryonic phase. Plant Mol Biol 73:481–492. https://doi.org/10.1007/s11103-010-9634-3
Uddenberg D, Valladares S, Abrahamsson M et al (2011) Embryogenic potential and expression of embryogenesis-related genes in conifers are affected by treatment with a histone deacetylase inhibitor. Planta 234:527–539. https://doi.org/10.1007/s00425-011-1418-8
Valero-Rubira I, Castillo AM, Burrell MÁ, Vallés MP (2023) Microspore embryogenesis induction by mannitol and TSA results in a complex regulation of epigenetic dynamics and gene expression in bread wheat. Front Plant Sci 13:1058421. https://doi.org/10.3389/fpls.2022.1058421
Wang F, Perry SE (2013) Identification of direct targets of FUSCA3, a key regulator of Arabidopsis seed development. Plant Physiol 161:1251–1264. https://doi.org/10.1104/pp.112.212282
Wang X, Niu QW, Teng C et al (2009) Overexpression of PGA37/MYB118 and MYB115 promotes vegetative-to-embryonic transition in Arabidopsis. Cell Res 19:224–235. https://doi.org/10.1038/cr.2008.276
Wang Y, Su J, Wang L et al (2011) The effects of 5-Aza-2′-deoxycytidine and trichostatin A on gene expression and DNA methylation status in cloned bovine blastocysts. Cell Reprogram 13:297–306. https://doi.org/10.1089/cell.2010.0098
Wen L, Li W, Parris S et al (2020) Transcriptomic profiles of non-embryogenic and embryogenic callus cells in a highly regenerative upland cotton line (Gossypium hirsutum L.). BMC Dev Biol 20:25–40. https://doi.org/10.1186/s12861-020-00230-4
Wickramasuriya AM, Dunwell JM (2015) Global scale transcriptome analysis of Arabidopsis embryogenesis in vitro. BMC Genomics 16:301. https://doi.org/10.1186/s12864-015-1504-6
Wójcik AM, Nodine MD, Gaj MD (2017) MiR160 and miR166/165 contribute to the LEC2-mediated auxin response involved in the somatic embryogenesis induction in Arabidopsis. Front Plant Sci 8:1–17. https://doi.org/10.3389/fpls.2017.02024
Wójcikowska B, Botor M, Morończyk J et al (2018) Trichostatin a triggers an embryogenic transition in Arabidopsis explants via an auxin-related pathway. Front Plant Sci 9:1353. https://doi.org/10.3389/fpls.2018.01353
Wójcikowska B, Jaskóła K, Gasiorek P et al (2013) LEAFY COTYLEDON2 (LEC2) promotes embryogenic induction in somatic tissues of Arabidopsis, via YUCCA-mediated auxin biosynthesis. Planta 238:425–440. https://doi.org/10.1007/s00425-013-1892-2
Wójcikowska B, Wójcik AM, Gaj MD (2020) Epigenetic regulation of auxin-induced somatic embryogenesis in plants. Int J Mol Sci 21:7 https://doi.org/10.3390/ijms21072307
Xu WS, Parmigiani RB, Marks PA (2007) Histone deacetylase inhibitors: molecular mechanisms of action. Oncogene 26:5541–5552. https://doi.org/10.1038/sj.onc.1210620
Xu Z, Wang F, Tu Y et al (2022) Transcriptome analysis reveals genetic factors related to callus induction in barley. Agronomy 12:749–766. https://doi.org/10.3390/agronomy12030749
Yamamoto A, Kagaya Y, Toyoshima R et al (2009) Arabidopsis NF-YB subunits LEC1 and LEC1-LIKE activate transcription by interacting with seed-specific ABRE-binding factors. Plant J 58:843–856. https://doi.org/10.1111/j.1365-313X.2009.03817.x
Yemets AI, Krasylenko YA, Lytvyn DI et al (2011) Nitric oxide signalling via cytoskeleton in plants. Plant Sci 181:545–554
Zalewski W, Orczyk W, Gasparis S, Nadolska-Orczyk A (2012) HvCKX2 gene silencing by biolistic or Agrobacterium-mediated transformation in barley leads to different phenotypes. BMC Plant Biol 12. https://doi.org/10.1186/1471-2229-12-206
Zavattieri MA, Frederico AM, Lima M et al (2010) Induction of somatic embryogenesis as an example of stress-related plant reactions. Electron J Biotechnol 13:1–9. https://doi.org/10.2225/vol13-issue1-fulltext-4
Zhang L, Zhang Y, Gao Y et al (2016) Effects of histone deacetylase inhibitors on microspore embryogenesis and plant regeneration in Pakchoi (Brassica rapa ssp. chinensis L.). Sci Hortic 209:61–66. https://doi.org/10.1016/J.SCIENTA.2016.05.001
Zhang TQ, Lian H, Zhou CM et al (2017) A two-stepmodel for de novo activation of wuschel during plant shoot regeneration. Plant Cell 29:1073–1087. https://doi.org/10.1105/tpc.16.00863
Zhou X, Zheng R, Liu G et al (2017) Desiccation treatment and endogenous IAA levels are key factors influencing high frequency somatic embryogenesis in Cunninghamia lanceolata (Lamb.) hook. Front Plant Sci 8:2054–2069. https://doi.org/10.3389/fpls.2017.02054
Zuo J, Niu Q-W, Frugis G, Chua N-H (2002) The WUSCHEL gene promotes vegetative-to-embryonic transition in Arabidopsis. Plant J 30:349–359. https://doi.org/10.1046/j.1365-313X.2002.01289.x
Żur I, Dubas E, Krzewska M et al (2015) Hormonal requirements for effective induction of microspore embryogenesis in triticale (× Triticosecale Wittm.) anther cultures. Plant Cell Rep 34:47–62. https://doi.org/10.1007/s00299-014-1686-4
Acknowledgements
The authors wish to thank Dr Justyna Wróbel-Marek for consultation of histological results.
Funding
This work was supported by a research grant from the National Science Centre in Poland (OPUS13 2017/25/B/NZ1/01615). This work has benefited from the support of IJPB’s Plant Observatory technological platforms. The IJPB benefits from the support of Saclay Plant Sciences-SPS (ANR-17-EUR-0007).
Author information
Authors and Affiliations
Contributions
Conceptualization: B.W., M.D.G., K.N.; methodology: K.N., B.W., M.G., and M.D.G.; formal analysis: K.N., B.W., A.E., P.Ż., M.D.G.; investigation: K.N., B.W., A.E., P.Ż., M.G., J.M., A.M.W., S.C., A.K.-W., J.Z.; data curation: K.N., B.W.; writing—original draft preparation: K.N., M.D.G.; writing—review and editing: M.D.G.; visualization: K.N., B.W., and M.D.G.; supervision: M.D.G.; project administration: M.D.G.; funding acquisition: M.D.G. All authors have read and agreed to the published version of the manuscript.
Corresponding author
Ethics declarations
Conflict of interest
The authors declare no competing interests.
Additional information
Communicated by: Izabela Pawłowicz
Publisher’s note
Springer Nature remains neutral with regard to jurisdictional claims in published maps and institutional affiliations.
Rights and permissions
Open Access This article is licensed under a Creative Commons Attribution 4.0 International License, which permits use, sharing, adaptation, distribution and reproduction in any medium or format, as long as you give appropriate credit to the original author(s) and the source, provide a link to the Creative Commons licence, and indicate if changes were made. The images or other third party material in this article are included in the article's Creative Commons licence, unless indicated otherwise in a credit line to the material. If material is not included in the article's Creative Commons licence and your intended use is not permitted by statutory regulation or exceeds the permitted use, you will need to obtain permission directly from the copyright holder. To view a copy of this licence, visit http://creativecommons.org/licenses/by/4.0/.
About this article
Cite this article
Nowak, K., Wójcikowska, B., Gajecka, M. et al. The improvement of the in vitro plant regeneration in barley with the epigenetic modifier of histone acetylation, trichostatin A. J Appl Genetics 65, 13–30 (2024). https://doi.org/10.1007/s13353-023-00800-9
Received:
Revised:
Accepted:
Published:
Issue Date:
DOI: https://doi.org/10.1007/s13353-023-00800-9